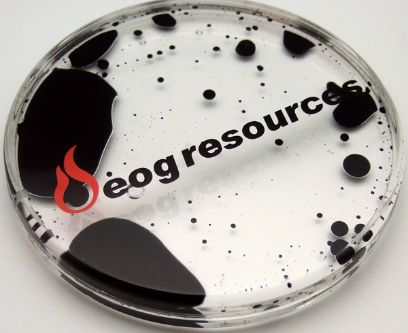
#FridayFun Cool liquid roller coasters, #custom filled coasters, #brand builder coasters and more

ow.ly/briG50L10qa
promoteyourbusiness.espwebsite.com/ProductResults…

maureen esch
@4exposure
helping businesses stay top of mind. STAND OUT with promotional products, incentives, awards, recognition, premiums - for all your custom needs.
ID: 183114315
https://promoteyourbusiness.espwebsite.com/ 26-08-2010 05:03:17
637 Tweet
394 Takipçi
852 Takip Edilen